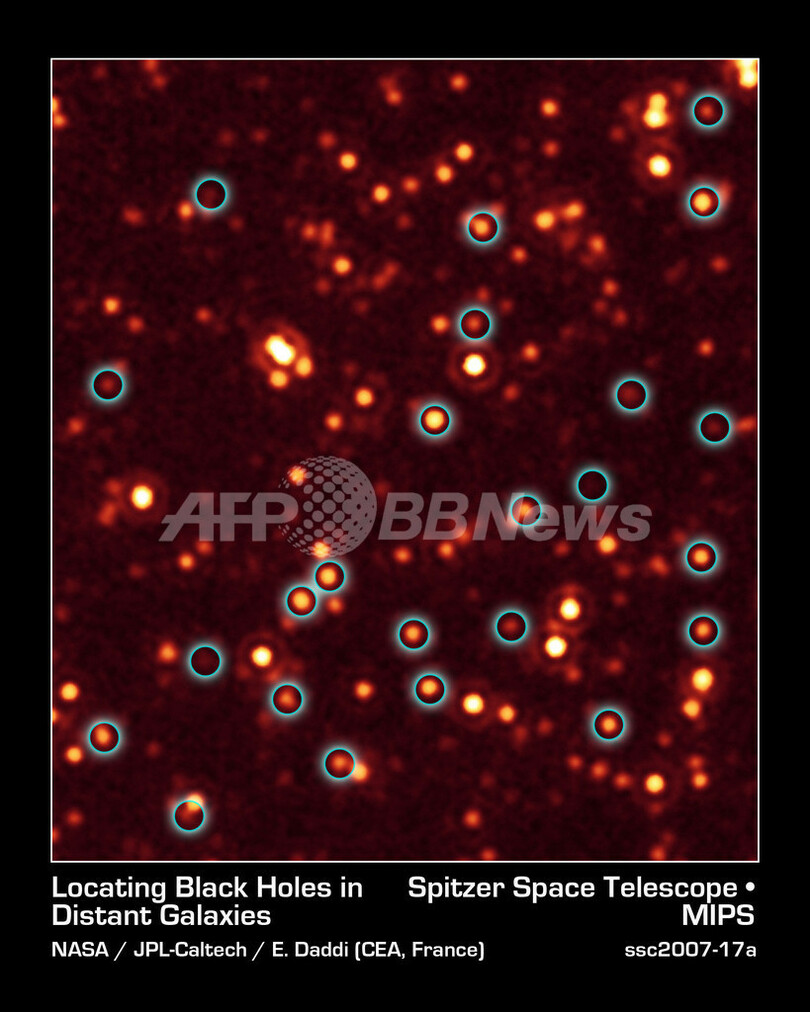

超巨大ブラックホール「クエーサー」数百個を発見、銀河の成長の謎に光
このニュースをシェア
【10月29日 AFP】各国の天文学者による国際チームは、地球から数十億光年離れた銀河で、拡大を続ける「超大質量」ブラックホール、「クエーサー」数百個を発見した。
一般的に、われわれが知る宇宙はおよそ140億年前に生まれたとされているが、この発見は、宇宙に存在するほとんどあるいはすべての大星雲は、発生からおよそ35億年経過した初期宇宙ではブラックホールを生み出すという仮説に対する、初めての直接的証拠になるという。
今回の発見によって、その銀河にはこれまで確認されていたより倍以上の数のブラックホールが存在していることが明らかになり、宇宙初期では数億個の拡大途中のブラックホールが存在していることを示唆している。
米アリゾナ州ツーソン(Tucson)にある米国立光学天文台(National Optical Astronomy Observatory、NOAO)のMark Dickinson氏は「調査前には、氷山の一角を見ているに過ぎなかったが、現在、われわれは氷山そのものを見ている」と語った。
天文学者は、いわゆる「活動中の」ブラックホールは、観測されたよりも多く存在するとの仮説を立ててきたが、長い間証拠をつかめずにいた。
新たに発見されたこの恒星状天体(クエーサー)は、巨大銀河の成長に関する根本的な疑問点の解決に役立つとされる。例えば、巨大銀河では星とブラックホールが同時進行で生成され、その後ブラックホールが成長して星の生成を阻害するようになることが分かった。
また、今回の観測では、以前考えられていたこととは異なり、銀河同士の衝突は銀河の成長にはそれほど重要ではない可能性も示唆しているという。
今回の観測結果は11月、米「Astrophysical Journal」誌に掲載される。(c)AFP/Marlowe Hood
一般的に、われわれが知る宇宙はおよそ140億年前に生まれたとされているが、この発見は、宇宙に存在するほとんどあるいはすべての大星雲は、発生からおよそ35億年経過した初期宇宙ではブラックホールを生み出すという仮説に対する、初めての直接的証拠になるという。
今回の発見によって、その銀河にはこれまで確認されていたより倍以上の数のブラックホールが存在していることが明らかになり、宇宙初期では数億個の拡大途中のブラックホールが存在していることを示唆している。
米アリゾナ州ツーソン(Tucson)にある米国立光学天文台(National Optical Astronomy Observatory、NOAO)のMark Dickinson氏は「調査前には、氷山の一角を見ているに過ぎなかったが、現在、われわれは氷山そのものを見ている」と語った。
天文学者は、いわゆる「活動中の」ブラックホールは、観測されたよりも多く存在するとの仮説を立ててきたが、長い間証拠をつかめずにいた。
新たに発見されたこの恒星状天体(クエーサー)は、巨大銀河の成長に関する根本的な疑問点の解決に役立つとされる。例えば、巨大銀河では星とブラックホールが同時進行で生成され、その後ブラックホールが成長して星の生成を阻害するようになることが分かった。
また、今回の観測では、以前考えられていたこととは異なり、銀河同士の衝突は銀河の成長にはそれほど重要ではない可能性も示唆しているという。
今回の観測結果は11月、米「Astrophysical Journal」誌に掲載される。(c)AFP/Marlowe Hood